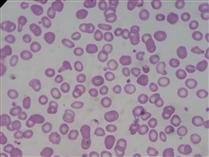
کم خوني فقر آهن کم خوني فقر آهن

پرواز بازگشت
در كمال خونسردي گفت: از تهران خبر داده اند كه زودتر ميپريم. همين!زودتر پريديم؟ نه!! بعد مشخص شد كه دوستان ايرانايري در بيروت اشتباه كرده اند و ساعت ورود هواپيما از تهران به بيروت 17:55 بوده است و به طور طبيعي بايد يك ساعت پس از آن پرواز كنيم و البته باز به طور طبيعي يك ساعت هم تأخير افزون بر آن نصيب ما شد.
موزه هايي كه روح دارند
ما عادت کرده ايم هر وقت براي ورود به يک موزه ورودي مي پردازيم و وارد آن مي شويم . با حوصله و وله به در و ديوار و اشياء موزه نگاه کنيم. جلوي هر غرفه بايستيم. فکر کنيم، سوال کنيم و به خاطر بسپاريم. و بعد اگر مقررات اجازه مي دهد عکس تهيه کنيم و يا کمي هم چانه بزنيم و قانون عکاسي ممنوع را زير سوال ببريم. و اگر متصدي موزه اجازه نداد...
جدايي آلزايمر از نادر و سيمين!
مدتي ميگذره از روزي که «جدايي نادر از سيمين» رو ديدم. اون موقع قصد کردم ستايش نامه اي درباره اش بنويسم، ولي بعد ديدم همه جا ازش تمجيد شده و حرفاي من تکراريه. گذشت تا همين چند روز پيش که «آلزايمر» رو ديدم.
وارد سينما که مي شدم فکر مي کردم...
خواب متصل ... !
نميدانم چه شد...
چشمانم را باز کردم سقف اتاق را ديدم،سفيد بود.نه بيشتر طوسي بود.
دوباره چشمانم را بستم.آمد مقابل چشمانم،ايستاده بود و داشت حرف مي زد.با من!
تصوير داشت اما صدايي نمي آمد...لبهايش تکان مي خوردند!نمي توانستم درک کنم موقعيتم را...اينکه کجايم...چرا نمي شنوم؟!
لحظه اي شنيدم که گفت:برگها!
دوباره صدا قطع شد.صدايش کردم.اما ...
دزد ناشي
فردا وقتي دزد قصه ي ما از کوچه اي رد مي شد آقاي «نان خشکي» را ديد که چند جلد از کتاب ها را روي قسمتي از چرخش مرتب چيده و داد مي زند: نان خووووووشک مي خريم! کتااااااب مي فروشيم!
آينه ي دل
آينه از روي طاقچه افتاد و شکست. تکه تکه شد. نزديک آمد نشست و تکه ي کوچکي از آينه ي شکسته را داد دستم. متعجب نگاهش کردم.گفت: خودت را در آن ببين. سعي کردم. به سختي توانستم بخش کوچکي از چشم و بيني ام را ببينم.
رو به من کرد و پرسيد: خودت را ديدي؟!
چکش نظارتي!
انسان هم فيلي است که ياد هندوستان کردنش زياد است. در نظام اداري ما به تبعيت از نظامهاي مادي عالم، همه ابزارهاي کنترل و نظارت، مادي و از بيرون است و کمتر از نظارت دروني سخن به ميان مي آيد. نظارت دروني و تضمين سلامت رفتار اداري فرد با تقويت تقوا و ايمان و اعتقاد به قيامت و حساب و کتاب بهترين ابزار کنترلي است که متاسفانه جدي گرفته نمي شود
کتابدار يا اطلاع رسان : ما که هستيم؟
کتابدار يا اطلاع رسان : ما که هستيم؟
مشکل از کجاشروع مي شود؟ از کي شروع مي شود؟ منشا آن چيست؟
از خودکتابداران؟ از دانشجويان اين رشته؟ ازفرهنگ مردم؟
خود راکتابدار بدانيم يا اطلاع رسان؟ آيا کتابداري بدانيم که صرفا با کتب و مجموعه منابع سروکاردارد و وظيفه او تنها امانت دادن کتاب وجريمه کردن آن هنگام تاخير در بازفرستادن مجموعه است؟ (که اميدوارم اين گونه نباشيم).
کم خوني فقر آهن
کمبود آهن يکي از شايعترين اشکال سوء تغذيه است. در جهان حدود 50% کم خوني ها مربوط به کمبود آهن مي باشد که باعث مرگ 841000 نفر در سال ميشود...کم خوني فقر آهن در خانمها شايعتر است ولي در صورتيکه در آقايان ديده شود حتماً بررسي سيستم گوارش از نظر خونريزي هاي گوارشي لازم است.
مهارت ارتباط با جنس مخالف
"مهارت ارتباط صحيح با جنس مخالف" که نباشد، بهتر است دختر و پسر همديگر را نبينند و توي دانشگاه هم از يکديگر جدايشان کنند!... "طرح تفکيک جنسيتي" که اجرا بشود، دختر و پسر حس مي کنند رفتار حاکميت با اونها، محترمانه نيست و البته که نيست! و مگر روابط خاص با جنس مخالف محترمانه است؟ رابطه اي که مدام تويش به جنبه هاي جنسي تاکيد مي شود، محترمانه است؟